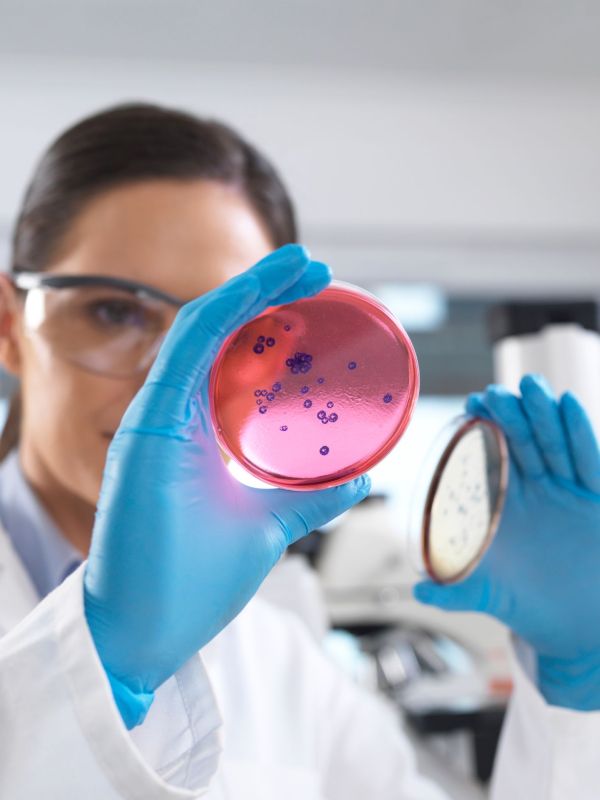

Kennisbank: Groep B Streptokokken | Verloskundig Centrum Bergwerg
Groep B streptokokken, lees hier meer.
Om te lezen
Groep B Streptokokken
Groep-B-streptokokken zijn bacteriën die bij veel mensen in de darmen of in de vagina en baarmoedermond voorkomen. Over het algemeen kan dit geen kwaad. Baby’s kunnen besmet raken tijdens de geboorte. In sommige gevallen leidt dit tot ziekteverschijnselen. De ziekte kan meestal goed behandeld worden met antibiotica.
Groep B-streptokokkeninfecties (GBS)
Groep B-streptokokkeninfecties (GBS(Groep-B-streptokokken)) zijn bacteriën die bij veel mensen van nature voorkomen in de darmen en/of de baarmoedermond en vagina. Meestal veroorzaken deze bacteriën geen ziekte. Wanneer de moeder draagster is van de bacterie kan een kind besmet raken tijdens de bevalling. In sommige gevallen leidt dit tot ziekte, ook wel GBS-ziekte genoemd. Tevens kan GBS ziekteverschijnselen veroorzaken bij volwassenen. [1]
Wat zijn symptomen van groep B-streptokokkeninfecties?
Besmetting met GBS uit zich bij pasgeborenen meestal als koorts, ademhalings- en voedingsproblemen. In ernstige gevallen kan een longontsteking, hersenvliesontsteking of bloedvergiftiging optreden die kan leiden tot de dood. Bij volwassenen kunnen groep B-streptokokken een blaasontsteking veroorzaken, hoewel dit meestal zonder ziekteverschijnselen verloopt. Daarnaast kan de bacterie bij vrouwen die recent bevallen zijn kraamvrouwenkoorts of wondinfecties veroorzaken, bijvoorbeeld na een keizersnede.
Besmetting en preventie van groep B-streptokokkeninfecties
Besmetting vindt plaats door middel van direct contact, zoals bij een moeder en een kind tijdens de bevalling. Baby’s worden ziek wanneer de bacterie het lichaam binnendringt. Bij langdurig gebroken vliezen kan besmetting van de foetus optreden. Pasgeborenen lopen risico op GBS-ziekte (ademhalings- en voedingsproblemen, koorts) en overlijden (ten gevolge van long-, bloed- of hersenvliesinfectie).
Wanneer het kind extra risico loopt (langdurig gebroken vliezen of dreigende vroeggeboorte) kun je ervoor kiezen uit voorzorg antibiotica te nemen via het infuus. Zwangere vrouwen met een risicofactor kunnen worden gescreend op dragerschap met GBS. In geval van dragerschap kan besloten worden antibiotica toe te dienen om de kans op besmetting van het kind tijdens de bevalling te verkleinen.
Hoe vaak komen groep B-streptokokkeninfecties voor?
In Nederland zijn één op de vijf mensen drager van groep-B-streptokokken zonder dat dit tot klachten leidt. Ongeveer 1 op de 1.000 pasgeboren kinderen wordt ziek door een GBS-infectie.
Screeningsbeleid
Zwangeren met risicofactoren (langdurig gebroken vliezen of dreigende vroeggeboorte) worden gescreend op GBS. Bij een positieve (of onbekende) screening, bij een eerder kind met GBS-ziekte en bij een bewezen urineweginfectie met GBS tijdens de zwangerschap is antibioticaprofylaxe tijdens de bevalling geïndiceerd. GBS in de urine is in principe een teken van dragerschap.
In onderstaand document lees je meer over de risico's van Groep B streptokokken.